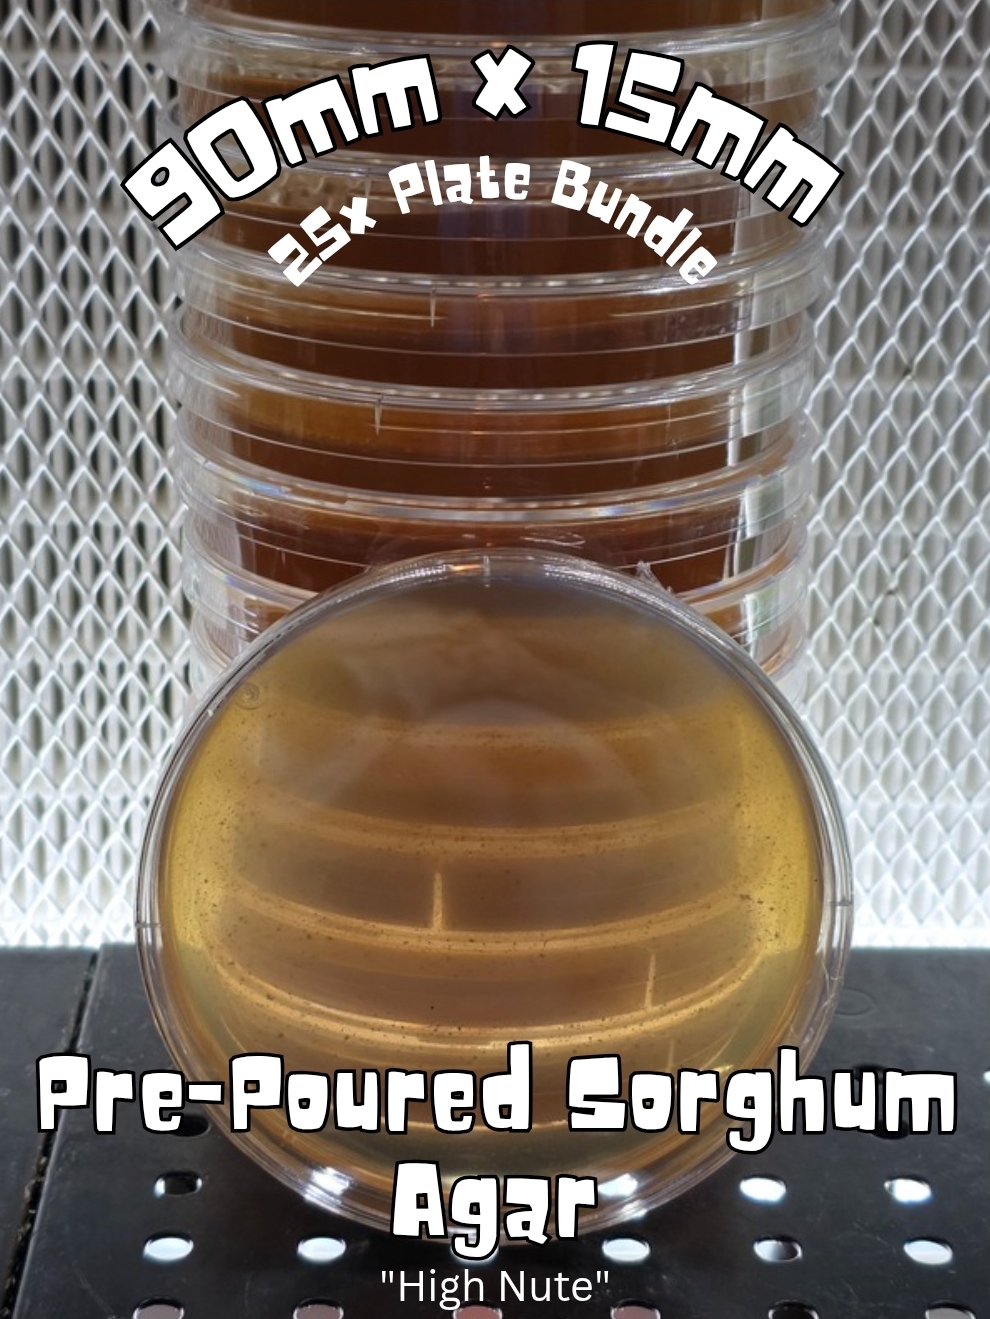

Only logged in customers who have purchased this product may leave a review.

MICoFroots
25x Prepoured “High Nute” Sorghum Agar (90mm)
$34.00
MICoFroots’ in-house, high nutrient, sorghum recipe, poured into 90mm x 15mm sterile petri dishes. Bundle of 25x. Ready to use.
All agar plates are poured and cooled in front of a 2’x4′ WhisperFlow laminar flow hood with a 4″ Certified HEPA filter and a MERV10 prefilter. Plates are poured, cooled and then wrapped before sitting for 3-5 days before shipping to ensure no contaminants are present. Single plate orders will come with one strip of parafilm. Prepoured agar plate orders of 10 or more will receive a roll of grafting tape for sealing plates. Customers have one week from time of package delivery to report any issue(s) with their prepoured agar order, with pics, to receive replacement(s). Failure to comply with this policy will result in not receiving a replacement OR refund!
Units Sold: 1
Active genetics for mycologists of every experience level! We’re here to provide the best quality cultures, spores and supplies on the market!
Shipping costs
| Shipping from | United States (US) |
| Within United States (US) | $10.00 |
National Shipping Details
| Minimum shipping charge per order | $10.00 |
| Maximum shipping charge per order | $10.00 |
| Free shipping if the order spend is over | $100.01 |

Reviews
There are no reviews yet.